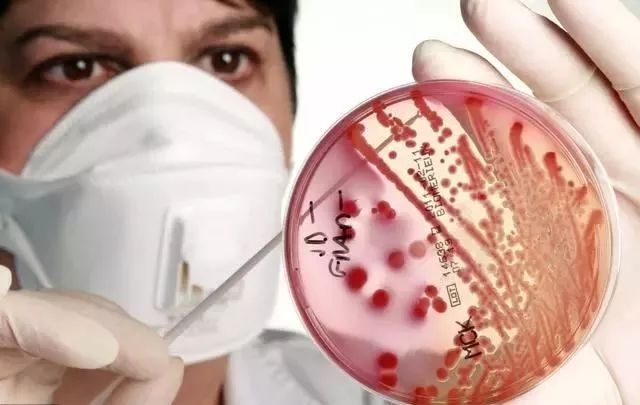
医用外科口罩与医用口罩有什么区别 46c7682e57d3457b98b1abd27eac4d01.jpeg

医用外科口罩与医用口罩有什么区别
*** 次数:1999998 已用完,请联系开发者***

康芝药业:生产成人及儿童用一次性医用口罩和医用外科口罩,当前库存...近期国家卫健委和疾控中心发通知要求和倡导公共场合戴口罩,康芝口罩以销定产的生产计划目前是否启动公司回答表示:您好,感谢您对公司的关注!公司生产及销售的口罩有:一次性使用医用口罩(成人及儿童)、医用外科口罩、医用防护口罩。目前公司口罩库存充足。谢谢!本文源自金融...

抗过敏必备!君格医用外科口罩独立包装正规一次性三层防飞沫抗病毒...在使用过程中要及时更换口罩,不要重复使用或者混搭不同品牌型号的口罩。通过此篇文章的介绍,相信您已经对君格医用外科口罩有了更深入... 评论和分享文章,并在方便的时候打赏并关注岩哥资讯,获取更多健康科普知识及生活常识。 查看文章精彩评论,请前往什么值得买进行阅读互动
∩△∩ 
4.9元100片的医用外科口罩在以前不敢想呀作者:我就看什么也不买宝子们,今天跟大家分享一款4.9元100一片的医用外科口罩,这是一种能够有效过滤空气中细菌和其他微粒的口罩,它通常用于手术室、诊所和其他医疗环境中,以及一些特定的工作场所和公共场合。随着疫情的肆虐,医用口罩的需求量越来越大,对于一般大众而言,购...

一个医用外科口罩能用多久?医生提醒:反复佩戴可能伤肺医用外科口罩是一种关键的个人防护装备,广泛应用于医疗机构、手术室和临床环境中。它们旨在降低医护人员和患者之间的感染风险,有效减少病原体在空气中的传播。一、医用外科口罩的使用时间A. 医用外科口罩的功能和原理医用外科口罩的功能和原理:医用外科口罩是一种设计用于...

德美舒一次性医用外科口罩作者:噗叽噗叽咪咪咪德美舒一次性医用外科口罩是一款非常受欢迎的口罩产品。根据文章的描述,这个口罩的质量非常好,戴起来舒服,而且颜色... 而且整个口罩的贴合度很高,完全不用担心戴着会有闷的情况,现在价格也相当便宜,还不赶紧入手嘛。阅读更多医用口罩精彩内容,可前往什么值...
ˋ▂ˊ 
福可安医用外科口罩口罩的佩戴体验和舒适度也得到了极大的关注。在当前疫情的背景下,我们应该时刻保持警惕,积极采取措施防范病毒的传播。福可安医用外科口罩将成为我们的重要护盾,保护我们的健康和安全。让我们共同携手,共度难关。阅读更多医用口罩精彩内容,可前往什么值得买查看

⊙^⊙ 沫么3倍通气医用外科口罩,安心呵护健康口罩已然成为了日常必备品。市面上很多口罩我也踩过雷,而这款沫么3倍通气医用外科口罩,价格美丽,颜值防护双在线,柔软舒适的耳带,透气精选的材质,就算是戴上一整天也不会感到闷闷的。阅读更多医用口罩精彩内容,可前往什么值得买查看

∪▂∪ 时尚与防护兼备!这款医用外科口罩,让你成为焦点!作为医用口罩,界面医用外科口罩的质量真的没话说。灭菌处理让我更加放心使用,而且成人尺寸适合大多数人使用。而且秋冬季节的时尚外观... 口罩很快就收到了满满一大盒。都是独立包装的,出门方便携带,带上没有任何异味,不勒耳朵。查看文章精彩评论,请前往什么值得买进行阅读互...
买的最多的口罩:袋鼠医生医用外科口罩产品评测及选购指南保证了口罩的卫生和安全。4. 款式多样:有多种款式和颜色供消费者选择,满足不同场合的需求。五、使用注意事项1. 佩戴前请洗手:在佩戴口罩... 都能得到及时的解答和处理。总的来说,袋鼠医生的医用外科口罩在市场上得到了良好的口碑。阅读更多医用口罩精彩内容,可前往什么值得买...

WELLDAY 维德 一次性三层无菌级医用外科口罩作者:Another小猫咪WELLDAY 维德 一次性三层无菌级医用外科口罩是一款备受好评的口罩产品。根据文章内容的分享和用户的真实感受,这款... 这款口罩不仅价格便宜,而且质量还不错,之前戴的口罩要么不透气,要么做工不行,这款口罩却不是这样。查看文章精彩评论,请前往什么值得买进...
∩﹏∩
坚果加速器部分文章、数据、图片来自互联网,一切版权均归源网站或源作者所有。
如果侵犯了你的权益请来信告知删除。邮箱:xxxxxxx@qq.com
上一篇:医用外科口罩与医用口罩有什么区别
下一篇:医用外科口罩与医用口罩有什么不同





